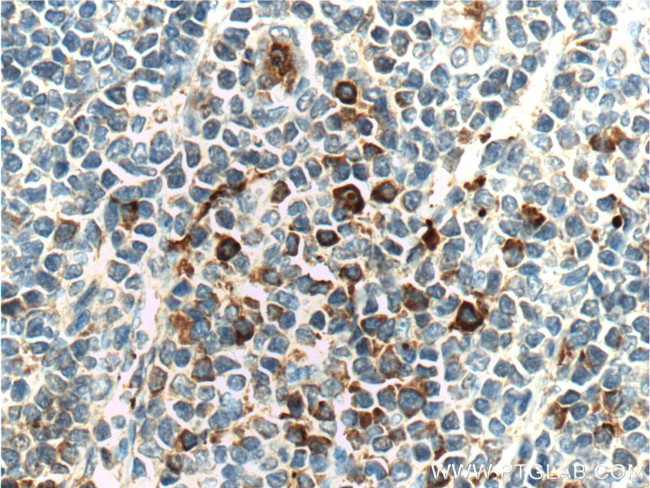
LRRC32 Antibody in Immunohistochemistry (Paraffin) (IHC (P))

Search
Proteintech
LRRC32 Polyclonal Antibody
{{$productOrderCtrl.translations['antibody.pdp.commerceCard.promotion.promotions']}}
{{$productOrderCtrl.translations['antibody.pdp.commerceCard.promotion.viewpromo']}}
{{$productOrderCtrl.translations['antibody.pdp.commerceCard.promotion.promocode']}}: {{promo.promoCode}} {{promo.promoTitle}} {{promo.promoDescription}}. {{$productOrderCtrl.translations['antibody.pdp.commerceCard.promotion.learnmore']}}
产品信息
26021-1-AP
种属反应
宿主/亚型
分类
类型
抗原
偶联物
形式
浓度
规格
纯化类型
保存液
内含物
保存条件
运输条件
产品详细信息
Immunogen sequence: PGLEVATGA LGGLEASLEV LALQGNGLMV LQVDLPCFIC LKRLNLAENR LSHLPAWTQA VSLEVLDLRN NSFSLLPGSA MGGLETSLRR LYLQGNPLSC CGNGWLAAQL HQGRVDVDAT QDLICRFSSQ EEVSLSHVRP EDCEKGGLKN INLIIILTFI LVSAILLTTL AACCCVRRQK FNQQYKA (477-662 aa encoded by BC070079 )
靶标信息
GARP, also known as leucine rich repeat containing 32, is a type I membrane protein with twenty-two leucine-rich repeats and a short intracytoplasmic region. GARP was identified based on the analysis of gene expression profiling of Treg and Th cells following TCR stimulation. Since GARP is expressed in CD4+, CD25+, FoxP3+ cells (Tregs), it may be a candidate for cell surface marker for Treg cells.
仅用于科研。不用于诊断过程。未经明确授权不得转售。
篇参考文献 (0)
生物信息学
蛋白别名: GARP; Garpin; Glycoprotein A repetitions predominant; Leucine-rich repeat-containing protein 32; Transforming growth factor beta activator LRRC32
基因别名: AI426318; CPPRDD; D11S833E; D11S833Eh; D7H11S833E; EG434215; GARP; LRRC32
UniProt ID: (Human) Q14392, (Mouse) G3XA59
Entrez Gene ID: (Human) 2615, (Mouse) 434215